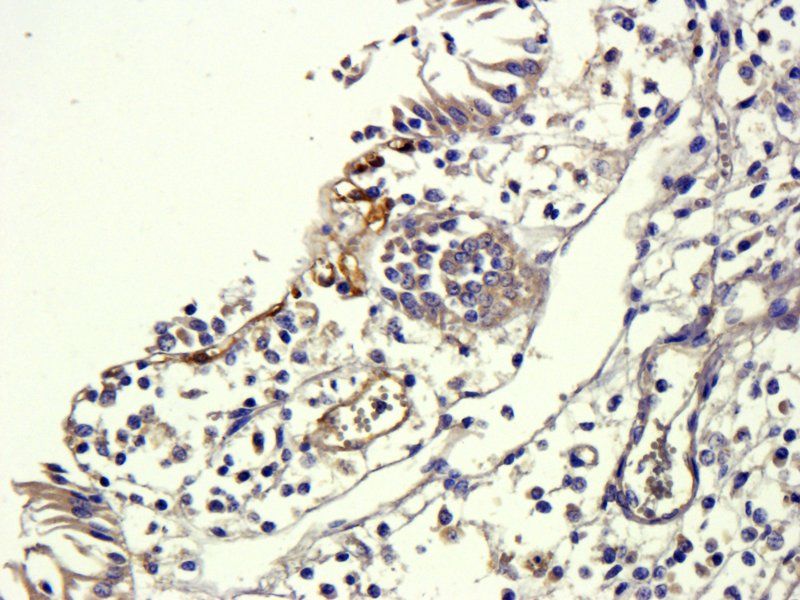
TGF beta 1 antibody抗体，orb11468

相关产品推荐更多 >
万千商家帮你免费找货
0 人在求购买到急需产品
- 详细信息
- 文献和实验
- 技术资料
- 抗体名:
TGF beta 1 antibody抗体
- 抗体英文名:
TGF beta 1 antibody
- 靶点:
TGF beta 1
- 浓度:
- 100 μg (in 200 μl): 0.5 mg/ml- 200 μg (in 400 μl): 0.5 mg/ml
- 应用范围:
ELISA, ICC, IF, IHC-P, WB
- 宿主:
Rabbit
- 保质期:
6-12个月
- 抗原来源:
详询
- 目录编号:
orb11468
- 级别:
科研级
- 库存:
88
- 供应商:
biorbyt
- 标记物:
Unconjugated
- 克隆性:
Polyclonal
- 形态:
10 mM PBS, 0.02% sodium azide
- 亚型:
IgG
- 免疫原:
KLH conjugated synthetic peptide derived from human TGF beta 1. Please contact us for the exact immunogen sequence. The peptide is available as orb374750.
- 规格:
15 ug
别名:anti-beta 1a antibody, anti-Camurati Engelmann disease antibody, anti-CED antibody, anti-Diaphyseal dysplasia 1 progressive antibody, anti-DPD1 antibody, anti-LAP antibody, anti-Latency-associated peptide antibody, anti-TGFB antibody, anti-Tgfb-1 antibody, anti-TGFbeta antibody, anti-TGF-beta1 antibody, anti-TGF-beta-5 antibody, anti-Transforming growth factor antibody, anti-Transforming Growth Factor beta 1 antibody, anti-TGFB1 antibody
免疫原:KLH conjugated synthetic peptide derived from human TGF beta 1. Please contact us for the exact 免疫原 sequence. The peptide is available as orb374750.
分子量:44 kDa
应用稀释比例:WB: 2μg/ml, IF/ICC: 1:500, IHC-P:1:400 - 800 (based on 0.5 mg/ml)
应用注释:This antibody can be used for WB, the correct bands. Predicted weight: 45-50 kDa Tested weight: 50kDa
纯度:Polyclonal antibodies are purified by peptide affinity chromatography
保存说明:Maintain refrigerated at 2-8°C for up to 2 weeks. For long term storage store at -20°C in small aliquots to prevent freeze-thaw cycles.
Pubmed:35509267, 39243827, 40638418, 40751072, 26261504
NCBI:000651, 41, 000660, 31
Entrez:7040
UniProt ID:P01137, P17246, P04202
Note:For research use only.

风险提示:丁香通仅作为第三方平台,为商家信息发布提供平台空间。用户咨询产品时请注意保护个人信息及财产安全,合理判断,谨慎选购商品,商家和用户对交易行为负责。对于医疗器械类产品,请先查证核实企业经营资质和医疗器械产品注册证情况。
 文献和实验
文献和实验tangqj 谁有TGF-beta的信号传导图?谢谢 kaige88 参见如下: kaige88 参见如下: 本文由丁香园论坛提供,想了解更多有用的、有意思的前沿资讯以及酷炫的实验方法的你,都可以成为师兄的好伙伴 师兄微信号:shixiongcoming
【求助】关于TGF-Beta,FN酶联免疫(ELISA)试剂盒的选择参与者:txl4fox我是要酶联免疫(ELISA)的方法测细胞上清液中的TGF-Beta,FN抗原的表达情况,关于ELISA试剂盒的选择我想请教几个问题:我想买酶标板自己包被一抗,那我应该如何选择ELISA试剂盒?有没有不带酶标板只带一抗,二抗,酶底物,以及底物显色剂而且够做五六张板的ELISA试剂盒?如果没有,是不是我应该分开订购?ELISA试剂盒从国外哪几个公司订购比较好同时又相对不会很贵?谢谢。参与者:风来了你说的市场
【求助】急求TGF-beta受体2高表达和低表达的大肠癌细胞
sofa623 各位老师,前辈,求教了,请问在国内和ATCC的大肠癌细胞系中,哪些是TGF-beta受体高表达,哪些是低表达呢,我自己找了很久,但是收获不大,哪位做过这方面研究的老师能不能指点一下,或者说明一下我该查哪些网站也好——我已经查阅了ATCC,上海细胞库的细胞系说明,还有pubmed上的相关文献,还是没有明确的说明的——先谢谢了 sofa623 哪位老师有相关的经验,请不吝赐教,谢谢,谢谢 基因小子
 技术资料
技术资料暂无技术资料 索取技术资料











